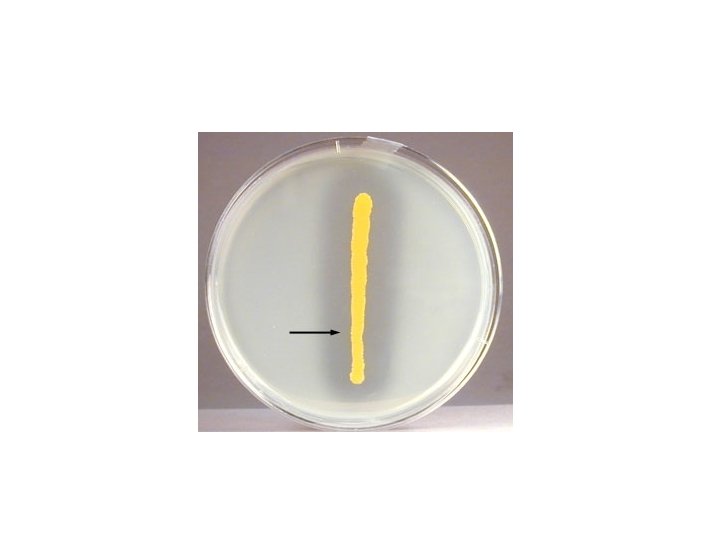

Biochemical Reactions Catalase Test Principle If organisms have

Biochemical Reactions

Catalase Test: • Principle: If organisms have catalase enzyme they will hydrolyze hydrogen peroxide (substrate) leading to production of oxygen (end product) 2 H 2 O 2 >> 2 H 2 O + O 2 • End point: air bubbles >> catalase positive No air bubbles >> catalase negative • Used to differentiate staphylococci from streptococci


Coagulase test: • Principle: if organisms have coagulase enzyme it will converts fibrinogen (plasma) to fibrin (clot) • This test is done by slide method or tube method • Used to differentiate between S. aureus (CPS) and other Staphylococcus species (CNS)



Oxidase Test: • Used to identify bacteria that produce cytochrome c oxidase enzyme • Principle: cytochrome c oxidase enzyme oxidizes the (reagent) Tetra. Methyl. Phenylene. Diamine (TMPD) to indophenol -purple color- (end product) in the presence of atmospheric oxygen • End point: purple color>> oxidase positive No purple color>> oxidase negative


DNAse test: • Principle: if organisms have deoxyribonuclease (DNAse) enzyme it will hydrolyse DNA in the media and give clear area around the colony after adding HCL • End point: clear halo around the colony>> DNAse positive No clear halo>> DNAse negative

Bile solubility test: • Used to differentiate Streptococcus pneumoniae (bile soluble) from other alpha- hemolytic Streptococcus like Streptococcus viridans (bile insoluble) • Add bile salt to the bacterial colony>> colony disappears>> bile soluble bacteria • Add bile salt to the broth: Clear>> bile soluble Turbid>> bile insoluble


Nitrate test: • Principle: if organisms have nitrate reductase enzyme it will reduce nitrate (NO 3) to nitrite (NO 2) which give red color after adding the reagents • Nitrate broth medium is used in this test. It contains nutrients and potassium nitrate as a source of nitrate. • End point: red color broth>> nitrate positive yellow color broth>> nitrate negative


Indol test: • Used to identify bacteria that produce tryptophanase enzyme • Principle: tryptophanase enzyme breakdown tryptophan (substrate) to indol (end product) and give red color ring after adding the reagent • Medium used: is tryptophan broth which contains the a. a trptophan • End point: red ring>> indol positive no red ring>> indol negative


Amino Acid Decarboxylation Test: • Principle: determines the ability of organisms to produce amino acid decarboxylase enzyme that removes carboxyl groups from amino acids • Medium used is decarboxylase base containing nutrients, dextrose and p. H indicators with added amino acids (either arginine, ornithine or lysine). The a. a content gives the broth an alkaline p. H. • Un inoculated broth is purple in color

• Bacteria first ferment dextrose to produce acids>> PH changes from alkaline (purple) to acidic (colorless-light yellow). • Following dextrose fermentation: Ø If org. produces the decarboxylase enzyme specific to the a. a in the tube, it will yield alkaline products>> p. H reverts to alkaline (purple). Ø If not, the broth remains acidic. Color stays colorlesslight yellow. • End point: if broth is yellow, the organism is decarboxylase -ve for that a. a. If the medium is purple, the organism is decarboxylase +ve for that a. a.


A. A Decarboxylation Results of some Enterobacteriaceae

Methyl Red- Vogues Proskaur (MR-VP): • Bacteria metabolize sugars by different pathways to produce either stable acidic end products or non- stable acids that quickly convert to neutral end products. • MR-VP broth is the medium in which both the Methyl Red and Voges-Prosakuer tests can be performed. It contains peptone, buffers, and either the sugar dextrose or glucose. • Organisms that metabolize sugars using the mixed acid pathway produce stable acids such as lactic acid, acetic acid and formic acid (remain acidic). • Organisms using the butylene glycol pathway produce unstable acids that are further metabolized to yield neutral end products such as acetoin and butanediol.

Methyl Red Test Principle and Results: • Tests for orgs. that use mixed acid fermentation of sugars • MR detects PH change and is +ve when the PH is acidic. • If broth turns red after adding MR reagent (methyl red), the result is positive. • If, after the reagent has been added, a copper-yellow color is present, the result is -ve

Vogues Proskaur Principle and Results: • Tests for bacteria that metabolize sugars by the bytylene glycol pathway • VP detects alcohols and is +ve when PH is neutral. • When VP reagents (VP 1, VP 2) are added to MR-VP broth that has been inoculated with an org. that uses the butylene glycol pathway, a red color is produced indicating a +ve result. • If, after the VP reagents have been added, a copperyellow color is present, the result is -ve.

Note: MR & VP can’t BOTH be positive; they test for different fermentation pathways, the bacteria will only be using one

Ureas test: • Light orange media, contain urea • Indicator: phenol red • Principle: If organism produce urea's enzyme, it will break down urea to ammonia and carbon dioxide, the PH will change from acidic to alkaline and the color of media will change from light orange to deep pink color (+ve) • If organism do not produce urea's enzyme, the media remain light orange(no color change) -ve


Citrate test: • Test the ability of organism to utilize citrate as a carbon source for the production of energy. • Citrate agar contains sodium citrate as the sole source of carbon, ammonium phosphate as the sole source of nitrogen , other nutrients, and the p. H indicator bromothymol blue. • Bacteria that can utilize citrate as their sole carbon source produce an enzyme, citrate permease to transport the citrate into the cell for the production of energy • The p. H change turns the bromthymol blue indicator from green to blue • End point: green color>> citrate –ve. blue color>> citrate +ve


Triple Iron Sugar Test (TSI): Composition of TSI: • Lactose, Sucrose and Glucose (10: 1) • Iron: Ferrous sulfate: Indicator of H 2 S formation • Phenol red: Indicator of acidification (It is yellow in acidic condition and red under alkaline conditions).

Interpretation of Triple Sugar Iron Agar Test: • Lactose and sucrose are both present in very large amounts (1%). If either one is fermented, a large amounts of acid are produced and the whole tube turns from red to yellow. Some species generate gases, which producing bubbles/cracks on the medium • Glucose is present in a very small amount (0. 1%) and if it is the only sugar fermented only a very small amount of acid can be produced from it. Therefore, the butt only become (yellow). Some species may also produce gas from glucose. Organisms that produce H 2 S react with the ferric sulfate to form black ferrous sulfide. • IF neither lactose/sucrose nor glucose is fermented, both the butt and the slant will be red.

K/A= red/yellow= glucose fermentation only = NLF

A/A= yellow/yellow= glucose and lactose and/or sucrose fermentation= LF

K/K= red/red= no fermentation

- Slides: 34